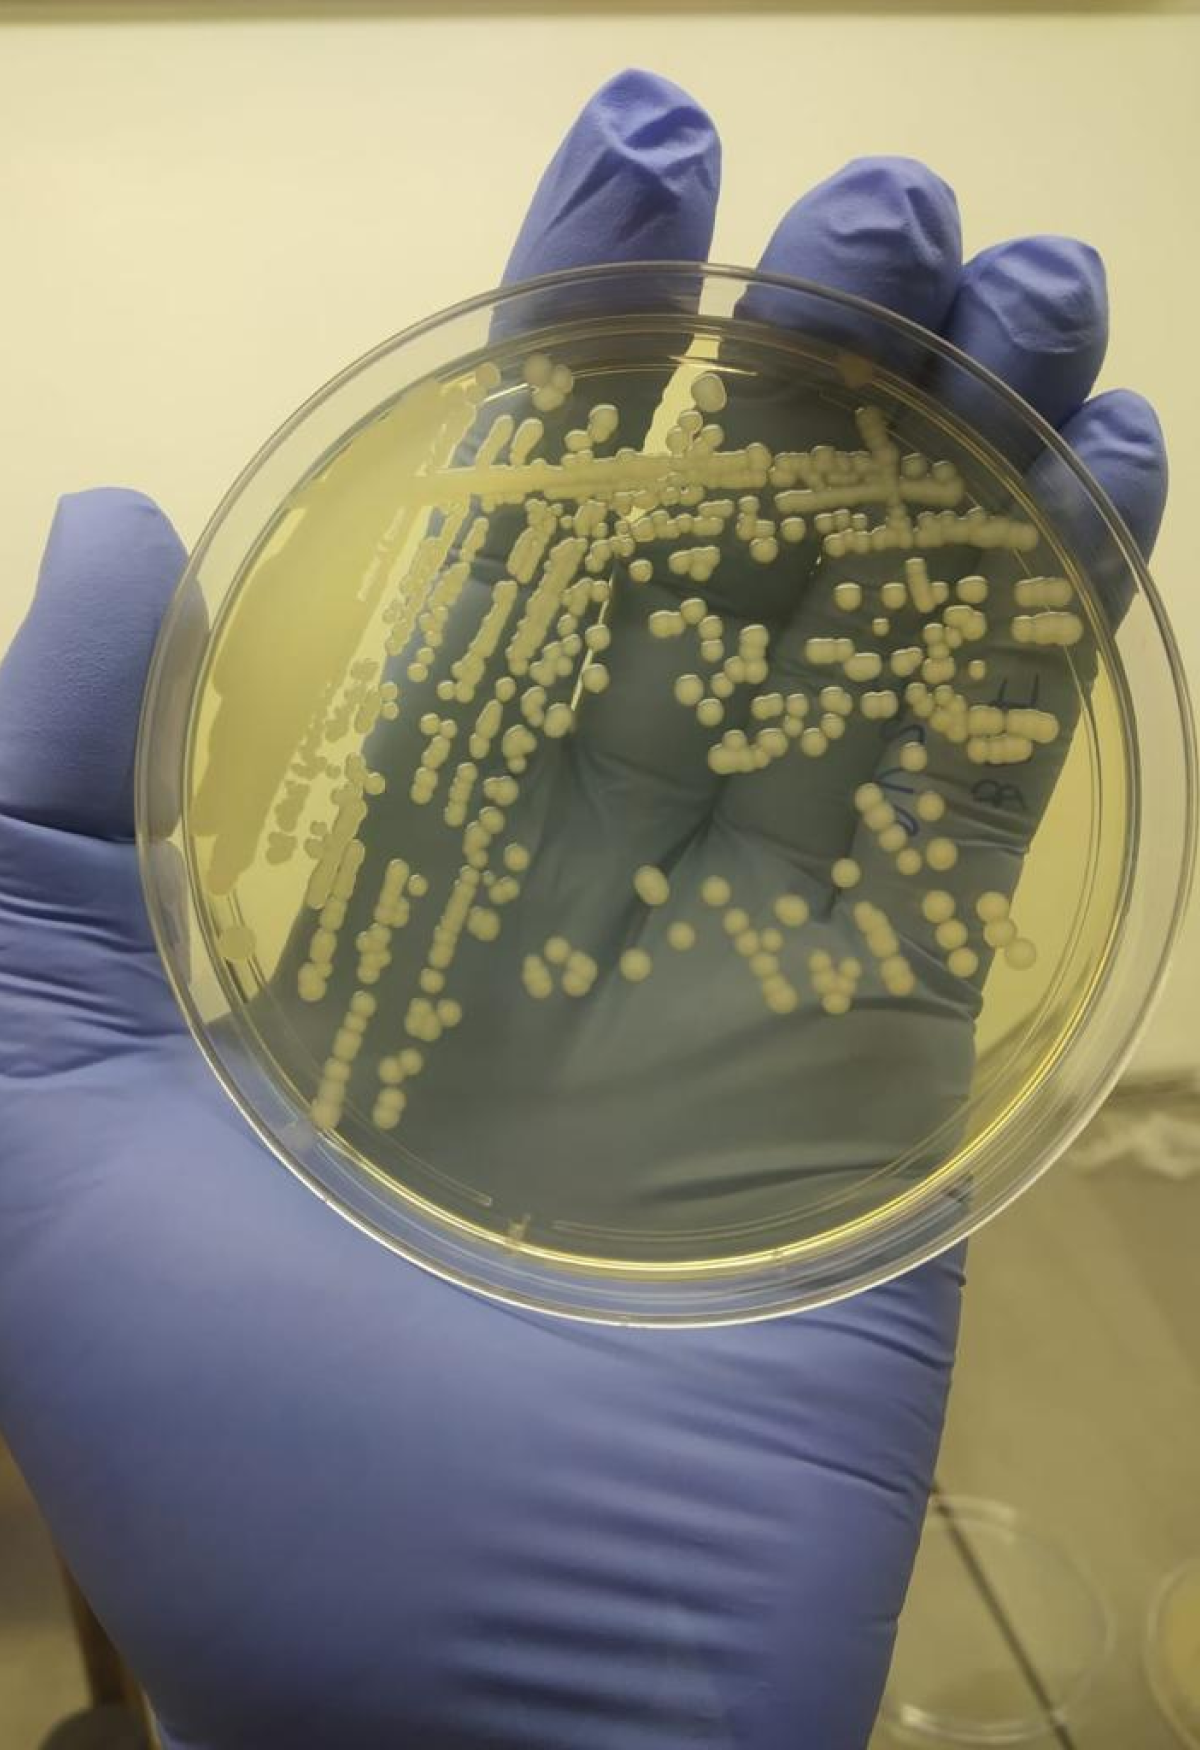

The Business Administration program organizes an international trip to Germany and the Czech Republic
The group visited technological and cultural hubs in European countries
 PhD Candidate in Biotechnology Awarded Sandwich Doctoral Scholarship at U.S. Hospital
PhD Candidate in Biotechnology Awarded Sandwich Doctoral Scholarship at U.S. HospitalLaura Molezini Investigates the Effects of Systemic Administration of the MMP-2 Enzyme in Mice, Focusing on Adipose Tissue and Perivascular Tissue
 Software Engineering Program Promotes Unaerp's Programming Marathon
Software Engineering Program Promotes Unaerp's Programming MarathonAimed at undergraduate students, the event focused on solving computational problems in teams
 18th Computer Engineering Challenge Encourages Creation of Solutions for Pet Care
18th Computer Engineering Challenge Encourages Creation of Solutions for Pet CareThe event took place on November 5th at the Bassano Vaccarini Theatre
 Article by Researchers from the Biotechnology Unit Published in Scientific Reports
Article by Researchers from the Biotechnology Unit Published in Scientific ReportsThe research, conducted at the Biosciences Laboratory, investigates metabolic syndrome in patients with gastrointestinal cancer
 A professor at Unaerp presents academic paper at a conference in the United States
A professor at Unaerp presents academic paper at a conference in the United StatesWith support from FAPESP, Professor Karina Pfrimer conducted a technical visit to the Stable Isotope Laboratory at the University of Wisconsin-Madison
 Professor Gives Lecture at International Congress in Colombia
Professor Gives Lecture at International Congress in ColombiaAt the event, Professor Karina Pfrimer gave a lecture on the role of nutrition in muscle health in relation to aging
 International Relations Program Launches Export Guide for Companies in the Ribeirão Preto Region
International Relations Program Launches Export Guide for Companies in the Ribeirão Preto RegionThe guide aims to instruct those interested in legislation, fees, and processes for transactions with companies abroad
 Alumna Launches Social Project for Children in the United States
Alumna Launches Social Project for Children in the United StatesMichelle Alvarez Donati created Kids Dental Care, a program that provides free dental care to low-income Hispanic, Brazilian, and American children
 Professor from Unaerp Guarujá stands out in one of the world's leading scientific journals
Professor from Unaerp Guarujá stands out in one of the world's leading scientific journalsThe article explores a new use for pinacidil, which was initially developed for blood pressure control
 The Architecture and Urbanism program hosts the exhibition “Casa UNA na UNE” in partnership with Grupo Mundo Robusti
The Architecture and Urbanism program hosts the exhibition “Casa UNA na UNE” in partnership with Grupo Mundo RobustiThe exhibition presents decoration projects for a bar, office, balcony, dining area, home, and two living rooms developed by Unaerp students
.png) Master’s student in Biotechnology receives honorable mention at the International Congress of the Brazilian Society of Genetics
Master’s student in Biotechnology receives honorable mention at the International Congress of the Brazilian Society of GeneticsBeatriz Borsani Sampaio dedicated herself to the study of genes modulated by natural products and synthetic analogs, under the guidance of Professor Ana Lúcia Fachin.
 Students from the Publicity & Advertising Program win awards at FestDigital 2024
Students from the Publicity & Advertising Program win awards at FestDigital 2024Agencies F5, Gênesis, and Resu stood out at the awards by winning Gold and Silver; the event honors the best advertising works in the audio and online segments
 Researchers from the Graduate Program in Biotechnology and Environmental Technology publish article in Biomass Journal
Researchers from the Graduate Program in Biotechnology and Environmental Technology publish article in Biomass JournalA study evaluated multispecies indices obtained by drones to detect and quantify the alga Kappaphycus alvarezii in commercial farming in Brazil
 Postgraduate Law Professor Selected to Teach at University of Sydney
Postgraduate Law Professor Selected to Teach at University of SydneyProfessor Edilson Vitorelli Diniz Lima, from the Postgraduate Program in Law at Unaerp, has been appointed as a Visiting Professor at the University of Sydney in Australia. The professor has expertise...
.png) Unaerp Hosts Visit from Texas A&M University Professor
Unaerp Hosts Visit from Texas A&M University ProfessorThe Law Program at the University of Ribeirão Preto welcomed Professor Luz Herrera from Texas A&M University School of Law on July 5. She was greeted by Professor Luiz Eugênio Scarpino Junior, the...
 Unaerp starts the semester with Diverse Academic and Cultural Program
Unaerp starts the semester with Diverse Academic and Cultural ProgramStarting August 5, Unaerp will kick off its traditional Freshman and Veteran Welcome and Integration Program, which greets the academic community for the second semester
.png) Unaerp Coordinator of Architecture and Urbanism Visits Partner Institution in Peru
Unaerp Coordinator of Architecture and Urbanism Visits Partner Institution in PeruOn July 8th and 9th, the coordinator of the Architecture and Urbanism Program at Unaerp, Professor Edson Salerno Junior, visited Universidad Católica de Santa María in Arequipa, Peru. During the visit,...
 Unaerp Professor and Researcher Appointed Full Member of Prestigious Sigma Xi
Unaerp Professor and Researcher Appointed Full Member of Prestigious Sigma XiProfessor André Pitondo da Silva, researcher in Microbiology and faculty member in the Graduate Programs in Biotechnology, Dentistry, and Environmental Technology, as well as in the undergraduate programs...
 5th International Law Symposium Explores "Conflicts in the Contemporary Order"
5th International Law Symposium Explores "Conflicts in the Contemporary Order"The International Relations and Law programs at Unaerp hosted the 5th edition of the International Law Symposium on May 23rd and 24th, focusing on "Conflicts in the Contemporary Order." The event took...
 Unaerp participates in NAFSA 2024 Conference
Unaerp participates in NAFSA 2024 Conference Between May 28th and 31st, Unaerp was present at the NAFSA 2024 Conference in New Orleans, United States. The event is the largest international education conference and facilitated strategic meetings...
 Guarujá Campus Professor to Teach Course in Spain
Guarujá Campus Professor to Teach Course in SpainUnaerp Guarujá will once again be represented internationally. Prof. Dr. Márcio Curvello from the Civil Engineering and Nursing Programs, will act as an instructor for the University of Coruña, in...
.png) Unaerp celebrates 100 years of excellence in teaching, research and community outreach
Unaerp celebrates 100 years of excellence in teaching, research and community outreachOn June 1st, the University of Ribeirão Preto, maintained by AERP (Ribeirão Preto Teaching Association), completes 100 years of history and excellence in quality in teaching, research and provision of...
 Software Engineering receives maximum evaluation, Concept 5, from MEC
Software Engineering receives maximum evaluation, Concept 5, from MECCoordinated by professor Edilson Carlos Caritá, the Software Engineering course was evaluated with Concept 5, maximum grade, awarded by the MEC in the course Recognition process. The Expert Committee...
.png) Law Professor Gives Lecture at International Congress "Together for Humanity"
Law Professor Gives Lecture at International Congress "Together for Humanity"Luiz Eugenio Scarpino Júnior, a professor in the Law program at Unaerp, supervisor of NEPCEx - the Center for Practical Teaching, Complementary Activities, and Extension, and an Alumnus of the Postgraduate...
 VI International Congress of the Ibero-American Network of Research on Social Security takes place in Málaga, Spain
VI International Congress of the Ibero-American Network of Research on Social Security takes place in Málaga, SpainOn September 26th and 27th, the VI International Congress of the Ibero-American Network of Research on Social Security will be held in Málaga, Spain. Under the theme "Challenges to Ensure Adequate and...
.png) Unaerp Hosts Visit from Professors and Representatives of Foreign Institutions
Unaerp Hosts Visit from Professors and Representatives of Foreign InstitutionsIn April, Unaerp hosted a visit from professors Paco Hulpiau and Kaat Janssens from Howest University of Applied Sciences, along with representatives from the Polytechnic Institute of Beja. The visitors...
 Launch of Herbal Remedies Based on Marigold and Cat's Claw in Jardinópolis
Launch of Herbal Remedies Based on Marigold and Cat's Claw in JardinópolisOn Monday, April 15th, the presentation event for new herbal remedies based on marigold and cat's claw was held at the Gininho Marchió Library and Student Center in Jardinópolis. These remedies are the...
 Unaerp Research Investigates the Efficacy of Curcumin on Cardiovascular Changes in Menopause
Unaerp Research Investigates the Efficacy of Curcumin on Cardiovascular Changes in MenopauseCurcumin, a compound found in turmeric, studied for its antioxidant and anti-inflammatory properties, is the focus of Professor Joslene Tilvikas de Sá's doctoral thesis in the Physical Education program....
.png) Unaerp Attended the FAUBAI 2024 Conference in São Paulo
Unaerp Attended the FAUBAI 2024 Conference in São PauloThe Annual Conference of the Brazilian Association for International Education (FAUBAI) took place from April 20th to 24th. With the theme "Inviting for a New Journey," the event welcomed approximately...
.png) Unaerp Choir Participates in International Festival held in Istria, Croatia
Unaerp Choir Participates in International Festival held in Istria, CroatiaThe Unaerp Choir took part in the 12th International Choirs and Orchestras Festival in Poreč, Istria, Croatia, held from April 9th to 13th. The group performed in the Historic Center of Poreč and at...
 Unaerp Ranked as 4th Best Private University in São Paulo
Unaerp Ranked as 4th Best Private University in São PauloThe University of Ribeirão Preto has been recognized as the 4th best private university in the state of São Paulo and stands at the 9th position among both public and private institutions in Brazil....
.png) Unaerp's Architecture and Urbanism Program Marks 10 Years of Foundation
Unaerp's Architecture and Urbanism Program Marks 10 Years of FoundationEstablished in 2014, Unaerp's Architecture and Urbanism course is a benchmark in the Ribeirão Preto region, evaluated with a Grade 4 by the Ministry of Education – MEC (in a range from 1 to 5). With...
 Biotechnology Unit Research Contributes to the Preservation of the Species Known as "Cat's Claw"
Biotechnology Unit Research Contributes to the Preservation of the Species Known as "Cat's Claw"Unaerp is collaborating with the Universidade Federal do Oeste do Pará (Ufopa), the Public Prosecutor's Office for the Environment, and the Archdiocese of Santarém in the production of a germplasm bank...
.png) Students and professors from Lafayette College Visit Unaerp Guarujá Campus
Students and professors from Lafayette College Visit Unaerp Guarujá CampusUnaerp Guarujá welcomed eight students and three faculty members from Lafayette College, located in Easton, Pennsylvania, United States, on March 11th. The guests were provided with technical insights...
.png) Law Students Awarded at the Model United Nations of the University of Coimbra
Law Students Awarded at the Model United Nations of the University of CoimbraUnaerp Law students Isabela Godoi Brettas and João Victor Idaló participated in the Model United Nations, a simulation of the United Nations General Assembly held from March 15 to 17 by the University...
.png) IFMSA Brazil – Unaerp promotes the event "Hemotalk: Action and Awareness"
IFMSA Brazil – Unaerp promotes the event "Hemotalk: Action and Awareness"Held in partnership with the Ribeirão Preto Hemocenter, the campaign aims to encourage the registration of bone marrow donors
.png) Unaerp's Research Investigates Control of Recurrent Candidiasis and Dermatophytosis
Unaerp's Research Investigates Control of Recurrent Candidiasis and DermatophytosisThe research project, coordinated by Professor Ana Lúcia Fachin, is funded by the São Paulo Research Foundation (FAPESP).
.jpg) Unaerp Celebrates 100-Year Journey with Historical Timeline
Unaerp Celebrates 100-Year Journey with Historical TimelineIn honor of Unaerp's centenary, our institutional portal proudly presents a timeline highlighting key milestones from the from the “Ribeirão Preto Teaching Association” in 1924 to the present day....
 Research Conducted at the Biotechnology Unit Highlighted in Trends in Biotechnology
Research Conducted at the Biotechnology Unit Highlighted in Trends in BiotechnologyResearch aims to develop a biopharmaceutical for the treatment of depressionThe article titled "Challenges in Recombinant Brain-Derived Neurotrophic Factor Production," authored by researchers from the...
%20(1).png) University of Coimbra Lecturer Gives Lecture at Bassano Vaccarini Theater
University of Coimbra Lecturer Gives Lecture at Bassano Vaccarini TheaterThe undergraduate program and Graduate Program in Law at Unaerp promoted the lecture "Jurisprudentialism and Person" last Thursday, the 22nd, at the Bassano Vaccarini Theater, given by Professor Ana Margarida...
 Unaerp promotes a calendar of cultural events to welcome freshmen and veterans
Unaerp promotes a calendar of cultural events to welcome freshmen and veteransWith the start of the academic semester, the Unaerp Sports, Culture and Wellbeing Center carries out, during the month of February, an intense cultural agenda to welcome students back to campus and promote...
 Ilha dos Arvoredos Becomes the First Tourist Attraction in the Americas to Receive Green Key Certification
Ilha dos Arvoredos Becomes the First Tourist Attraction in the Americas to Receive Green Key CertificationIlha dos Arvoredos now boasts the Green Key seal, the primary global award for excellence in social responsibility and sustainability in the tourism sector, making it the first and only tourist attraction...
 Unaerp establishes partnership with Municipal Secretariat for environmental preservation in Ribeirão Preto
Unaerp establishes partnership with Municipal Secretariat for environmental preservation in Ribeirão PretoUnaerp welcomed representatives from the Municipal Secretariat of the Environment on Tuesday, February 6, to formalize a technical-scientific cooperation agreement aimed at optimizing environmental processes...
 Unaerp Medicine Student's Study Gains Global Recognition for Cannabis-Opioid Relationship
Unaerp Medicine Student's Study Gains Global Recognition for Cannabis-Opioid RelationshipGabriel Costa, a standout student in Unaerp's Medicine program, has taken the lead in publishing an article titled "The Impact of Cannabis on Non-Medical Opioid Use Among Individuals Receiving Pharmacotherapies...
 Computer Engineering Student Achieves 13th Place in Hyundai/CREA-SP Challenge
Computer Engineering Student Achieves 13th Place in Hyundai/CREA-SP ChallengeRocha, who is currently an intern at the University's Department of Chemical Engineering, shares that the project, initiated this year, was based on ABNT PR 2030, incorporating and adapting the UN Sustainable...
.jpg) Graduate Program in Law carries out program with Benemérita Universidad Autónoma de Puebla
Graduate Program in Law carries out program with Benemérita Universidad Autónoma de PueblaThe program aimed to deepen students' knowledge in the course of "Latin American Social Protection."
 Unaerp welcomes professor from Portugal to lecture on Consumer Law in Europe
Unaerp welcomes professor from Portugal to lecture on Consumer Law in EuropeDuring the event, Frota discussed new rules and precautions for the financing of collective actions in Europe.
 Unaerp Wins the 20th Agro Vision Award
Unaerp Wins the 20th Agro Vision AwardUnaerp was represented by the Director of Teaching, Research, and Extension, Professor Rafael Tomaz de Oliveira
 Faculty Member from the Graduate Program in Environmental Technology Wins USP Outstanding Thesis Award
Faculty Member from the Graduate Program in Environmental Technology Wins USP Outstanding Thesis AwardProfessor and researcher from the Graduate Program in Environmental Technology and the Medicine course at Unaerp, Guilherme Sgobbi Zagui, emerged victorious in the 12th edition of the USP Outstanding Thesis...
 Unaerp welcomes professor from the University of Gloucestershire
Unaerp welcomes professor from the University of Gloucestershire Closer ties result from DCINI's participation in the International Virtual Exchange Conference (IVEC 2023)
 Health Research Center to Conduct Targeted Clinical Studies for the Ribeirão Preto Region
Health Research Center to Conduct Targeted Clinical Studies for the Ribeirão Preto RegionUnaerp, HapVida NotreDame Intermédica Group and Science Valley inaugurate a center focused on scientific and technological development in healthcare
 Journalism program promotes screening of the documentary “Reports of a War Correspondent in the Amazon”
Journalism program promotes screening of the documentary “Reports of a War Correspondent in the Amazon”The Unaerp Journalism program, in partnership with Agência Repórter Brasil, promoted the screening of the documentary “Reports of a War Correspondent in the Amazon”, a tribute to the English journalist...
 XIII International Relations Symposium discusses sustainable development and climate change
XIII International Relations Symposium discusses sustainable development and climate changeThe event featured lectures and round tables with alumni and guest professors
 Law students from the Guarujá Campus simulate a UN session
Law students from the Guarujá Campus simulate a UN sessionLaw students from UNAERP Guarujá simulated a session of the United Nations (UN) Security Council. The practical activity corresponded to an academic project in the General Theory of the State and Political...
 Delegation from the Unaerp Law program participates in a Congress in Lima/Peru
Delegation from the Unaerp Law program participates in a Congress in Lima/PeruCoordinator Sebastião Silveira speaks during the ceremony of his investiture as honorary professor at Universidad San Martin de Porres. Professor and coordinator Sebastião Sergio da Silveira and teachers...
 Unaerp participates in the EAIE 2023 Conference
Unaerp participates in the EAIE 2023 ConferenceFrom September 26th to 30th, Unaerp participated in the EAIE 2023 Conference (European Association for International Education) in Rotterdam, the Netherlands. Considered the largest international education...
 6th edition of InterUnaerp has the participation of 650 athletes
6th edition of InterUnaerp has the participation of 650 athletesBetween September 22nd and October 3rd, the UNAERP undergraduate sports league, promoted the InterUnaerp 2023. The competition, which included 650 athletes, was organized by the Department of Sports, Culture...
 Unaerp open resistration for the 24th CONIC
Unaerp open resistration for the 24th CONICThe Unaerp 24th CONIC - Scientific Iniciation and Research Congress will be held online with presentations and evaluations of papers by digital means. With the theme "The emergence of the climate issue...
%20(1).jpg) Unaerp participates in the 75th NAFSA Conference
Unaerp participates in the 75th NAFSA ConferenceVanessa França Bonini Panico and Lucas da Costa Ferrari at the 75th NAFSA ConferenceThe University of Ribeirão Preto – Unaerp attended the NAFSA 2023 Conference, which took place from May 30 to June...
 Unaerp receives representatives from universities in England and Peru
Unaerp receives representatives from universities in England and PeruProfessors from the University of Huddersfield and the Catholic University of Santa Maria participated in a meeting with the Institution's Board of Directors and coordination of the Architecture and Urbanism...
 Unaerp attended the FAUBAI Conference 2023
Unaerp attended the FAUBAI Conference 2023Event took place between April 15th and 19th, in Belo Horizonte
 Students of the Business Management Program participates in a technical visit to the Colorado company
Students of the Business Management Program participates in a technical visit to the Colorado companyThe activity was carried out last Tuesday, April 11
 Lecturer at the Polytechnic of Turin gives short course "Aerosol Technology and Air Quality"
Lecturer at the Polytechnic of Turin gives short course "Aerosol Technology and Air Quality"Event was open to the community and held in a hybrid way, by Google Meet
.jpg) University of Paris Ouest-Nanterre La Défense’s Professor teaches course at Unaerp
University of Paris Ouest-Nanterre La Défense’s Professor teaches course at UnaerpEvent was promoted by the Graduate Program in Law on April 13th and 14th
 Unaerp professor participates in a technical visit at Technische Universität Braunschweig, in Germany
Unaerp professor participates in a technical visit at Technische Universität Braunschweig, in GermanyThe objective was to promote a collaborative partnership in a research project for the collection and recovery of PET packaging resources
 With maximum score, MEC renews Unaerp accreditation
With maximum score, MEC renews Unaerp accreditationWith Grade 5, the Institution consolidates itself in the select group of Brazilian universities ranked among the best in the country
.png) UNAERP researcher is awarded a FAPESP scholarship for international research
UNAERP researcher is awarded a FAPESP scholarship for international researchThe researcher says that the study seeks to develop a new toothpaste formulation containing nanoparticles of calcium phosphate to control tooth caries
 Researchers publish article in Revista AIDIS de Ingeniería y Ciencias Ambientales: Investigación, desarrollo y practica
Researchers publish article in Revista AIDIS de Ingeniería y Ciencias Ambientales: Investigación, desarrollo y practicaA study by researchers from the Graduate Program in Environmental Technology and from the Chemical Engineering Program at Unaerp was highlighted in the latest edition of Revista AIDIS de Ingeniería y...
Scientific partnership between UNESP and Unaerp identifies superbug that affects tilapias in Brazil
Scientific partnership between UNESP and Unaerp identifies superbug that affects tilapias in BrazilA survey by the Universidade Estadual Paulista - UNESP, carried out in partnership with Unaerp, described, for the first time worldwide, the multiresistant Klebsiella pneumoniae bacterium (popularly known...
.png) International Office promotes pre-boarding meeting with International Mobility students
International Office promotes pre-boarding meeting with International Mobility studentsLast Thursday, the 8th, the Unaerp International Office held the Pre-Departure Meeting with students who will participate in the International Mobility Program in the first semester of 2023. Students...
 Unaerp received the 19th Agro Vision Award
Unaerp received the 19th Agro Vision AwardYesterday, December 8, Unaerp received the 19th Prêmio Visão Agro (19º Agro Vision Award). The University accumulates tradition and experience of more than 40 years in programs and research in areas...
.png) Unaerp offers its students courses taught in English
Unaerp offers its students courses taught in EnglishUnaerp Business program opens enrollment for courses taught in English in the first half of 2023 for the morning, afternoon and evening periods
.png) Unaerp is visited by the representatives of the American Consulate
Unaerp is visited by the representatives of the American ConsulateOn the 4th, UNAERP received Gerry Kaufman, Education and Culture Attaché at the US Consulate in São Paulo, and Wesley Oliveira, Cultural Affairs Advisor at the Consulate General. The purpose of the visit...
.png) Unaerp Nutrition Program promotes webinar with Peruvian Institution
Unaerp Nutrition Program promotes webinar with Peruvian InstitutionThe Unaerp Nutrition program, in partnership with Carrera de Nutrición y Dietética at Universidad San Ignácio de Loyola (USIL), in Peru, promoted the International Webinar: Nutrition in Physically Active...
 Unaerp receives visit from Italian researcher
Unaerp receives visit from Italian researcherOn August 11th, UNAERP received an international visit from engineer Paolo Tronville, professor at the Department of Energy at the Polytechnic Institute of Turin, Italy. The researcher maintains a history...
 Professor participates in the 20th Brazilian Congress of International Law
Professor participates in the 20th Brazilian Congress of International LawProfessor Danilo Garnica Simini, from UNAERP International Relations and Law programs, was invited to participate as a speaker at the 20th Brazilian Congress of International Law. Held between the 24th...
.png) Unaerp participates in the largest international education fair in Europe
Unaerp participates in the largest international education fair in EuropeUnaerp was present at the European Association for International Education - EAIE 2022 Annual Conference, which took place between the 13th and 16th of September, in Barcelona, Spain. Considered the largest...
.png) Unaerp opens call for incoming students in 2023
Unaerp opens call for incoming students in 2023The International Office opens call for incoming students interested in studying at Unaerp in Brazil during the first academic semester from early February to end June and/ or the second semester from...
.png) Architecture and Urbanism program promotes online collaborative activities in partnership with UACJ from Mexico
Architecture and Urbanism program promotes online collaborative activities in partnership with UACJ from MexicoThis semester, the Architecture and Urbanism program started an activity in the “Collaborative Online International Learning (COIL)” modality with the Mexican institution Universidad Autónoma de Ciudad...
 Unaerp welcomes the Director of Global Health from Des Moines University and Campus b representative
Unaerp welcomes the Director of Global Health from Des Moines University and Campus b representativeOn Thursday, 11th, Unaerp received the Director of Global Health from the North American University, Des Moines University (DMU), Sondra Schreiber and Talita Alves, representative of Campus b, an organization...
 Professor at Unaerp participates in a study on the risks of using electronic cigarettes by pregnant women
Professor at Unaerp participates in a study on the risks of using electronic cigarettes by pregnant womenThe use of e-cigarettes during pregnancy may be linked to newborns with low birth weight, decreased breastfeeding, neuromotor development disorders, lower-than-ideal head circumference and more chances...
.png) Doctoral student in Law is awarded a co-financing scholarship with France
Doctoral student in Law is awarded a co-financing scholarship with FranceAuthored by the student Ana Carolina Pedrosa Massaro, the doctoral research project entitled “Guardianship of the Rights of the Unborn Consumer in Front of Surrogacy in Brazil and France”, developed...
 Professor from Unaerp Guarujá Campus participates in the International Forum on the Atlantic Ocean
Professor from Unaerp Guarujá Campus participates in the International Forum on the Atlantic OceanPost-doctoral professor Luciane Maranho, from Unaerp Guarujá, participated as a facilitator of the scientific event Fórum All-Atlantic Ocean Research Alliance 2022, an international online meeting organized...
 Unaerp participates in NAFSA 2022, the largest international education fair in the world
Unaerp participates in NAFSA 2022, the largest international education fair in the worldThe University of Ribeirão Preto - Unaerp was present at the NAFSA 2022 Annual Conference, which took place from May 31 to June 3, in Denver, in the United States. Considered as the largest international...
 Unaerp student works in Alzheimer's vaccine research
Unaerp student works in Alzheimer's vaccine researchAmong the mysteries that involve the human mind is Alzheimer's Disease. Despite being considered the most common form of neurodegenerative dementia in the elderly, it is not yet known how the disease develops...
 Nature Pharmacy Program is recognized by PAHO/WHO
Nature Pharmacy Program is recognized by PAHO/WHOUnder the coordination of researcher Ana Maria Soares Pereira, professor of the Master's and Doctoral Program in Biotechnology at Unaerp, Nature Pharmacy Program (in Portuguese: Farmácia da Natureza)...
 Journalism student is finalist in international competition
Journalism student is finalist in international competitionUnaerp Journalism student, Brenda Marchiori, is the only Brazilian finalist in the University Journalism category, in the 2022 edition of the Journalistic Excellence Contest, organized by the Inter American...
 Unaerp signs a Research Agreement with Fiocruz
Unaerp signs a Research Agreement with FiocruzThe Rector, Professor PhD Suzelei de Castro França, signed the Bilateral Technical-Academic Cooperation Term, between the Oswaldo Cruz Foundation - Fiocruz and Unaerp, last Friday (29). The objective...
 International Relations program promotes course on the war in Ukraine
International Relations program promotes course on the war in UkraineOpen to the academic community of Unaerp and the external community, the event consists of four meetings, held on Wednesdays
 Unaerp professor participates in scientific mission in Spain
Unaerp professor participates in scientific mission in SpainTreatment of brain injuries resulting from chronic neurodegenerative diseases is the objective of the study by Professor Dr. Renê Beleboni
 Unaerp Law program received the OAB Recommend Quality Hallmark 2022
Unaerp Law program received the OAB Recommend Quality Hallmark 2022OAB is the Brazilian Lawyer Association, the highest entity representing Brazilian lawyers
 XXXIII Physiotherapy Conference celebrates 35 years of the program
XXXIII Physiotherapy Conference celebrates 35 years of the programThe event took place from November 23 to 25, remotely and with face-to-face mini-courses
 UNAERP IS WINNER OF THE 18TH AWARD VISÃO AGRO
UNAERP IS WINNER OF THE 18TH AWARD VISÃO AGROThe award was yesterday; the University won in the category “Universities and Educational Institutions”
 Representative of Unaerp Guarujá Swimming wins two medals in Sul-Americano Master
Representative of Unaerp Guarujá Swimming wins two medals in Sul-Americano MasterJoão Vitor Nascimento won the title of South American champion in the 400 Medley and runner-up in the 200 Medley
 Unaerp holds award ceremony for the 22nd CONIC
Unaerp holds award ceremony for the 22nd CONICThe event took place in person, in Block C of the campus
 Unaerp receives the Socially Responsible Institution Hallmark from ABMES 2021/2022
Unaerp receives the Socially Responsible Institution Hallmark from ABMES 2021/2022The University has been part of the Social Responsibility Day initiative since its first edition, in 2005
 ARCHITECTURE AND URBANISM PROGRAM PARTICIPATES IN THE “PROYECTOS EN RED” IN ARGENTINA
ARCHITECTURE AND URBANISM PROGRAM PARTICIPATES IN THE “PROYECTOS EN RED” IN ARGENTINAProject by the Universidad Blas Pascal, in Cordoba, promotes a closing event on October 22, at 1:00 pm
 UNAERP PROFESSOR ATTENDS THE 'II INTERNATIONAL CO-GOVERNANCE CONGRESS'
UNAERP PROFESSOR ATTENDS THE 'II INTERNATIONAL CO-GOVERNANCE CONGRESS'During the event, held from October 9th to 12th, Professor Luiz Eugenio Scarpino Junior, from the Law program, spoke about cooperation and dialogue among public institutions and civil Society.
 DANIEL BOZUTTI JOINS THE WINNING TEAM OF THE GLOBAL EDUCATOR CHALLENGE 2021
DANIEL BOZUTTI JOINS THE WINNING TEAM OF THE GLOBAL EDUCATOR CHALLENGE 2021The theme of this year's edition was “Risk Management in Global Supply Chains”
 UNAERP RESEARCHERS ARE TOP SCIENTISTS IN LATIN AMERICAN RANKING
UNAERP RESEARCHERS ARE TOP SCIENTISTS IN LATIN AMERICAN RANKINGAD Scientific Index search ranked 453 Latin American universities based on individual scientific performance of researchers
 Registration for the 22nd CONIC is now open
Registration for the 22nd CONIC is now openWith the theme "Science and Technology in Combating the Pandemic", Congress will be held online on November 17th
 Ambassador of the European Union in Brazil gives lecture for Unaerp students and professors
Ambassador of the European Union in Brazil gives lecture for Unaerp students and professorsOnline event, with diplomat Ignácio Ybáñez, celebrated 15 years of the International Relations Program
 Lecture: "Current Challenges for Human Rights"
Lecture: "Current Challenges for Human Rights"August 26th at 19h30. Online event
 Lecture “The Brazilian Fantastic Four and All-One Leadership
Lecture “The Brazilian Fantastic Four and All-One LeadershipOnline event, on August 19, 2021
 UNAERP HIGHLIGHTS IN POLYTECHNIC UNIVERSITY OF TURIN ONLINE MAGAZINE
UNAERP HIGHLIGHTS IN POLYTECHNIC UNIVERSITY OF TURIN ONLINE MAGAZINEPublished article cites study of the Unaerp Master and Doctoral Program in Environmental Technology
 Former Unaerp student publishes article in Tensões Mundiais (world tensions) Magazine
Former Unaerp student publishes article in Tensões Mundiais (world tensions) MagazineCamila Perdono analyzed women's participation in World War II
 UNAERP TRIBUTE TO GUARUJÁ
UNAERP TRIBUTE TO GUARUJÁThe city celebrates today (06/30) 87 years
 Unaerp celebrates 22 years in Guarujá
Unaerp celebrates 22 years in GuarujáTradition, teaching quality and excellence in academic training are the hallmarks of Unaerp, which today celebrates the Guarujá campus 22 years
 A Tribute by Unaerp to the 165th Anniversary of Ribeirão Preto
A Tribute by Unaerp to the 165th Anniversary of Ribeirão PretoThe city celebrates its 165th anniversary on June 19th
 3rd Webinar on Chemical Engineering and Architecture and Urbanism had international participants
3rd Webinar on Chemical Engineering and Architecture and Urbanism had international participantsThe event discussed issues related to the environment, pandemic and urban spaces
 International Colloquium on Africa brings together relevant reserarchers from differente countries
International Colloquium on Africa brings together relevant reserarchers from differente countriesThe event begins the 15th anniversary celebrations of the International Relations program
 UNAERP CELEBRATES 97 YEARS OF HISTORY AND REAFFIRM ITS COMMITMENT TO THE COMMUNITY AND QUALIFIED EDUCATION
UNAERP CELEBRATES 97 YEARS OF HISTORY AND REAFFIRM ITS COMMITMENT TO THE COMMUNITY AND QUALIFIED EDUCATIONThe institution is currently evaluated by INEP/MEC as the tenth best university in the state of São Paulo
 UNAERP TEACHER IS NAMED REVIEWER OF THE STF CONSTITUTIONAL STUDY JOURNAL
UNAERP TEACHER IS NAMED REVIEWER OF THE STF CONSTITUTIONAL STUDY JOURNALInvitation was made by the President of the Supreme Federal Court of Brazil, Luiz Fux
 Unaerp is evaluated among the 10 best universities in the State of São Paulo
Unaerp is evaluated among the 10 best universities in the State of São PauloThe result released by INEP / MEC on Friday, 23, also ranks Unaerp as the fifth private HEI in the state
 Prof. Vanessa Bonini gives a lecture at the 17th SEMESP Regional Conference
Prof. Vanessa Bonini gives a lecture at the 17th SEMESP Regional ConferenceOnline event, which took place during the morning of this Friday, 19, addressed the challenges of higher education in this pandemic moment
 Business Program offers courses in English
Business Program offers courses in EnglishThe courses count on the participation of Brazilian and foreign students
 Unaerp researchers publish genome of bacteria resistant to all antibiotics
Unaerp researchers publish genome of bacteria resistant to all antibioticsThe study was coordinated by André Pitondo da Silva and published in the journal Infection, Genetics and Evolution
 UNAERP TEACHER BOOK IDENTIFIES UNIVERSAL STRUCTURE OF LANGUAGE
UNAERP TEACHER BOOK IDENTIFIES UNIVERSAL STRUCTURE OF LANGUAGEPublished by the publisher Elsevier, the work has professor Dionéia Motta Monte-Serrat as co-author
 Research investigates medicinal plants cultivation on the coast
Research investigates medicinal plants cultivation on the coastGarden Project uses Unaerp Guarujá Campus and Ilha dos Arvoredos as a place for experiments with plants with medicinal properties
 Unaerp professor participates in event at Argentine university
Unaerp professor participates in event at Argentine universityArchitecture and Urbanism professor from Unaerp, will participate in the International Online Week at Universidad Blas Pascal (UBP)
 UNAERP PHYSIOTHERAPY PROGRAM GETS MAXIMUM RATING AT ENADE 2019
UNAERP PHYSIOTHERAPY PROGRAM GETS MAXIMUM RATING AT ENADE 2019Medicine, Pharmacy, Nutrition, Physical Education and Production Engineering were evaluated with the concept 4
 Law area of Unaerp is highlighted in special edition
Law area of Unaerp is highlighted in special editionRevide Jurídica is focused on the Law area and brings interviews and reports about the world of law in the current scenario
 UNAERP PERFORMS MORE THAN 500 THOUSAND SERVICE PER YEAR TO THE POPULATION
UNAERP PERFORMS MORE THAN 500 THOUSAND SERVICE PER YEAR TO THE POPULATIONOn National Philanthropy Day, the balance of the University is also positive in the number of scholarship grants
 Unaerp researchers publish the world's first report of bacterial species causing dental infection
Unaerp researchers publish the world's first report of bacterial species causing dental infectionStudy was published in a renowned international scientific journal
 In online format, International Symposium of Integrated Sciences is with open registration
In online format, International Symposium of Integrated Sciences is with open registrationEvent will be mediated by technologies and will take place from November 3rd to 5th
Revide Magazine “Ciência em Ribeirão Preto” shows studies of international relevance and records the history of research in the city
 Renowned professors debate the transformations of the current world and their reflexes in Law
Renowned professors debate the transformations of the current world and their reflexes in LawLive marked the beginning of the 2nd semester for law students
Participants present preliminary architectural study for a multi-family vertical condominium planned for the city
Two Unaerp students are among the winners of the third edition of HackRibeirão, which took place on October 5 and 6, at Supera Parque de Inovação e Tecnologia, in Ribeirão Preto. Wesley de Oliveira...
QUALITY RESEARCH OF BRAZILIAN HIGHER EDUCATION RATE UNAERP AMONG THE COUNTRY'S BEST PRIVATE INSTITUTIONS
Professor Sawhney presented the lecture on “Transforming Business Productivity and Enhancing Employee Quality of Life”
The study analyzed one of the microorganisms that cause most hospital infections and have developed greater resistance to antibiotics in recent years
The meeting brought together members of the national board and the deliberative council of the entity and representatives of Faubai's regional and segments
The International Mobility Program opens call to receive applications from international students until October 31st.
 UNAERP MEDICAL SCHOOL PARTICIPATES IN AN ACADEMIC CONFERENCE AT MADRID UNIVERSITY
UNAERP MEDICAL SCHOOL PARTICIPATES IN AN ACADEMIC CONFERENCE AT MADRID UNIVERSITYThe event took place between the 24th and 30th of June 2019
 UNAERP CARRIES OUT THE VII BIOTECHNOLOGY WINTER COURSE
UNAERP CARRIES OUT THE VII BIOTECHNOLOGY WINTER COURSEThe Program takes place the whole week
 The Athletics League of Unaerp (Launaerp) won the first place in the 3rd Division of the Inter-Athletics Cup (CIA)
The Athletics League of Unaerp (Launaerp) won the first place in the 3rd Division of the Inter-Athletics Cup (CIA)The 5th edition of the CIA brought together 94 varsities from institutions in 40 cities, from 07 states of the country
The group was received by the Secretary of Institutional Communication of the Mercosur Parliament
The Heart Failure Congress is the largest worldwide congress promoted by the European Society of Cardiology
THE PROGRAM HAS THE CONCENTRATION AREA ON COLLECTIVE RIGHTS AND CITIZENSHIP
III International Colloquium on Communication Research in the Digital Age was promoted by the Universidad San Ignacio de Loyola - USIL
The event took place in Washington, DC, USA, with the participation of more than 100 countries
 INTERUNAERP 2019
INTERUNAERP 2019The event organization collected clothes and food for donations
 UNAERP PARTICIPATES IN THE 31ST FAUBAI CONFERENCE
UNAERP PARTICIPATES IN THE 31ST FAUBAI CONFERENCEThe conference was opened by the Brazilian Congresswoman Tabata Amaral
University is mentioned together with educational institutions and institutions that foster innovation in report on digital economy and entrepreneurship
The study was chosen from 800 abstracts
The Event of the Paulista Institute of Creative Cities and Cultural Identities (PICCCI) is aimed at students attending Architecture, Social Service and International Relations Programs
 UNAERP INAUGURATES FIRST MEDICINE PROGRAM IN GUARUJÁ CITY
UNAERP INAUGURATES FIRST MEDICINE PROGRAM IN GUARUJÁ CITYThe solemnity at the Unaerp Guarujá campus was marked by emotion and was attended by the university directors, incoming students, authorities, representatives of the medical class and guests
 UNAERP BUSINESS MANAGEMENT COURSE STARTS CLASSES
UNAERP BUSINESS MANAGEMENT COURSE STARTS CLASSESThe courses are part of Unaerp International Programs
 CAPES COORDINATOR LECTURES AT UNAERP
CAPES COORDINATOR LECTURES AT UNAERPProfessors and students attending the Master and Undergraduate in Law programs participated in the event
 UNAERP RESEARCHERS PARTICIPATE IN THE FOCUS ON CORE ACADEMIC SKILLS COURSE
UNAERP RESEARCHERS PARTICIPATE IN THE FOCUS ON CORE ACADEMIC SKILLS COURSEUNAERP, through the Division of National and International Cooperation (DCINI), last week promoted the course "Focus on core academic skills", a workshop on the development of skills in scientific communication...
 VANESSA BONINI PANICO PARTICIPATES IN THE FAUBAI 2016 CONFERENCE
VANESSA BONINI PANICO PARTICIPATES IN THE FAUBAI 2016 CONFERENCEThe Coordinator of DCINI – The Division of International and National Cooperation of UNAERP, Vanessa Bonini Panico, participated as Executive Secretary of the annual conference of FAUBAI - Brazilian...
UNAERP's courses in Physical Education, Nursing, Pharmaceutical sciences, Physiotherapy, Medicine, Nutrition, Dentistry and Social Work received a grade 4 in CPC / Enade MEC 2016.
Dentistry and Pharmaceutical Sciences of UNAERP are among the 10 best courses, from the private institutions of the country, according to the Folha University Ranking (RUF), released on Monday, September...
 UNAERP’S DIVISION OF NATIONAL AND INTERNATIONAL COOPERATION COORDINATOR PARTICIPATES IN EDUCATIONAL EVENTS IN SPAIN
UNAERP’S DIVISION OF NATIONAL AND INTERNATIONAL COOPERATION COORDINATOR PARTICIPATES IN EDUCATIONAL EVENTS IN SPAINThe coordinator of DCINI (The division of national and international cooperation), Vanessa Bonini Panico, was in Spain from September 12 to 19 participating in three events linked to the education internationalization.
 UNAERP PARTICIPATES IN 1ST FAIR “STUDY IN BRAZIL”
UNAERP PARTICIPATES IN 1ST FAIR “STUDY IN BRAZIL”UNAERP was invited to participate in the 1st Fair “Study in Brazil”, which took place between April 19 and 20, in Lima, Peru, at Pontificia Universidad Católica del Peru - PUCP.
 EXCHANGE OFFICE PROMOTES PRE-BOARDING MEETING WITH PARTICIPANTS OF THE UNAERP INTERNATIONAL MOBILITY PROGRAM
EXCHANGE OFFICE PROMOTES PRE-BOARDING MEETING WITH PARTICIPANTS OF THE UNAERP INTERNATIONAL MOBILITY PROGRAMOn Friday, 15th, UNAERP Exchange Office held the Pre-boarding Orientation Meeting with the students participating in the International Mobility Program - PROMOBI.
 PARTICIPATING STUDENT OF UNAERP INTERNATIONAL MOBILITY PROGRAM CONQUEST SCHOLARSHIP TO STUDY AT UNIVERSITY OF CANADA
PARTICIPATING STUDENT OF UNAERP INTERNATIONAL MOBILITY PROGRAM CONQUEST SCHOLARSHIP TO STUDY AT UNIVERSITY OF CANADAUNAERP International Relations student Luiza Fachini, participant in the PROMOBI – UNAERP International Mobility Program, won the ELAP - Emerging Leaders in the Americas Program for financial assistance...
 THE UNIVERSITY OF COIMBRA REPRESENTATIVE VISITS UNAERP
THE UNIVERSITY OF COIMBRA REPRESENTATIVE VISITS UNAERPYesterday, 10/04, the director of the International and Interinstitutional Relations Office of Coimbra Medicine Faculty, Professor Marília Dourado, representative of the University of Coimbra, UNAERP...
 INTERNATIONAL INTERNSHIP PROGRAMS WAS THE LECTURE THEME AT UNAERP
INTERNATIONAL INTERNSHIP PROGRAMS WAS THE LECTURE THEME AT UNAERPThe Global Partnership Coordinator, Tamara Ellenhorn, was at UNAERP last 13th, delivering lectures to students, coordinators, professors and staff on international internship programs.
 FRENCH INSTITUTION REPRESENTATIVE VISITS UNAERP
FRENCH INSTITUTION REPRESENTATIVE VISITS UNAERPUNAERP Exchange Office received on the 19th the visit of the representative Sophie Picavet, Director of International Affairs at Sup'Biotech, a partner French institution.
UNAERP Committee IFMSA - International Federation of Medical Students Associations promotes another edition of the Teddy Bear Campaign. It will take place at Nave da Saudade Daycare – Jardim Zara / Ribeirão...
 UNAERP VISITS INSTITUTIONS IN CHILE AND FRANCE
UNAERP VISITS INSTITUTIONS IN CHILE AND FRANCELast weeks, representatives from the Division of National and International Cooperation (DCINI) of UNAERP visited partner institutions in France and Chile.
 EXCHANGE CENTER SHALL SEND 10 STUDENTS ABROAD BY MOBILITY PROGRAM
EXCHANGE CENTER SHALL SEND 10 STUDENTS ABROAD BY MOBILITY PROGRAMUNAERP, through Exchange Office, will send ten undergraduate students to study, for six months abroad, through its International Mobility program.
 UNAERP ATHLETE WIN GOLD IN THE PAN AMERICAN SWIMMING MASTERS
UNAERP ATHLETE WIN GOLD IN THE PAN AMERICAN SWIMMING MASTERSThe athlete of UNAERP / SME Swimming team, Lisiane Destro, won a gold medal for the set of four modalities at the Pan American Swimming Masters in Orlando, USA, which took place between July 28th and August...
 NATIONAL AND INTERNATIONAL INTERINSTITUTIONAL COOPERATION DIVISION MAKES ANOTHER EDITION OF UNIVERSALIZE
NATIONAL AND INTERNATIONAL INTERINSTITUTIONAL COOPERATION DIVISION MAKES ANOTHER EDITION OF UNIVERSALIZEUNAERP’s Division of National and International Cooperation (DCINI) held another edition of Universalize last Wednesday, 08/08.
 INTERNATIONAL EDUCATION IS A MEETING THEME
INTERNATIONAL EDUCATION IS A MEETING THEMEThe Brazilian Association for International Education (FAUBAI) is promoting today, at UNAERP, the Southeast Regional Meeting FAUBAI-2017 to discuss management processes for the higher education internationalization.
 UNAERP PARTICIPATES IN CONFERENCE ON INTERNATIONALIZATION OF EDUCATION
UNAERP PARTICIPATES IN CONFERENCE ON INTERNATIONALIZATION OF EDUCATIONUNAERP sent a delegation from the Division of National and International Cooperation – DCINI and the Exchange Office to the 30 th Brazilian Association for International Education Conference
















